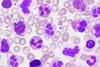
white-blood-cells-image

Izzy Wood (Drug Target Review)
 News
NewsPrimary cilia's role in cartilage regeneration after growth plate fractures
Activation of the Hedgehog signalling pathway through cilia holds promise for promoting cartilage repair and overcoming growth plate injuries.
 News
NewsHPV vaccine cost reimbursement could hinder vaccine access
Bare minimum reimbursement rates could be why some clinics may be struggling to offer HPV vaccination in the US.
 News
NewsMSK1’s importance for cognitive benefits
New study uncovers role of a neuronal protein kinase called mitogen- and stress-activated protein kinase 1 (MSK1) in mediating the cognitive benefits of environmental enrichment.
 News
NewsNew computational tool may fuel vaccine development
La Jolla biologists harness machine learning and computational tools to make sense of immune system data.
 News
NewsNewly discovered mechanism behind cognitive decline in aging
US researchers say new mechanism could lead to new drugs and therapies to treat normal cognitive decline in aging.
 News
NewsAlcohol-associated liver disease linked to abnormal splicing deregulation
Splicing deregulation is potential drug target and diagnostic tool, but can be affected by alcohol consumption and thus chronic liver disease.
 News
NewsAre female mice better protected against obesity?
The University of California underwent a mouse study disclosing underlying sex differences in mice for obesity.
 News
NewsExtracellular vesicles could slow spread of fibrosis
US researchers studied the extracellular vesicles of fibrosis and find potential avenue for new treatments and therapeutics.
 News
NewsHarnessing machine learning for early cancer detection in primary care
Machine learning (ML) presents a promising opportunity to revolutionize early cancer detection in primary care, addressing the challenges associated with diagnostic errors and improving patient outcomes. The potential of ML in this field is highlighted in a recent paper published in Oncoscience
 News
NewsBodybuilding supplement may help delay Alzheimer’s
US researchers uncover that body building supplement: HMB, may help stop the progression of Alzheimer’s disease.
 News
NewsA structural insight into HIV drug-resistance mechanisms
New Salk Institute, US, research could lead to the development of new HIV therapeutics that overcome resistance to existing drugs.
 News
NewsNovel targets identified for treatment of schistosomiasis
Researchers from Brazil discovered that survival of the parasitic worm that cause the disease schistosomiasis, depends on expression of a specific type of RNA. In animal trials, inhibition of the molecule interrupted the infection.
 News
NewsNew cancer diagnostics can predict chemotherapy response in triple negative breast cancer
US researchers innovate cancer diagnostics using Kinase Inhibitor Pulldown Assay, or KIPA, to search for proteins they could target to control tumour growth.
 News
NewsTargeting immune cells may help treat atrial fibrillation
New MGH study finds that macrophages and macrophage-produced proteins contribute to heartbeat irregularities, thus targeting these cells can aid atrial fibrillation treatment.
 News
NewsEngineered nanostructures enhance immune system’s ability to combat cancer
Important step achieved by US researchers as stable and potent immune therapy delivery system eradicates tumours in mouse models of melanoma, colon, and breast cancer, while preventing the formation of future tumour.
 News
NewsInvestigating heart disease through arterial calcification and repair mechanisms
Professor at Texas Tech University's Department of Biological Sciences has been granted an Innovative Project Award by the American Heart Association to delve into the intricacies of atherosclerosis, a condition responsible for artery thickening and severe health complications.
 News
NewsDouble face of RNase as a treatment for systemic autoimmune diseases
Japanese research shows that treating systemic autoimmune diseases with RNases can be detrimental, depending on the composition of the immune complex.
 Article
ArticleNavigating the challenges and opportunities of AI in drug development and personalised medicine
This article is the second part of Drug Target Review’s Izzy Wood’s discussion with Olivia Cavlan, Chief Corporate Development and Strategy Officer at Alchemab Therapeutics Ltd, exploring the role of AI in target discovery, its applications in personalised medicine, and the evolving landscape of pharmaceutical development.
News
NewsSpecialised white blood cells could lead to more preventative treatments
Australian researchers analyse the way specialised white blood cells produce an immune response, which could lead to the development of preventative treatments for cancer and infectious diseases.
- News
New guidelines for diagnosing Alzheimer's disease
Guidelines unveiled at AAIC 2023 using blood biomarkers offer faster and more effective Alzheimer's diagnosis.



